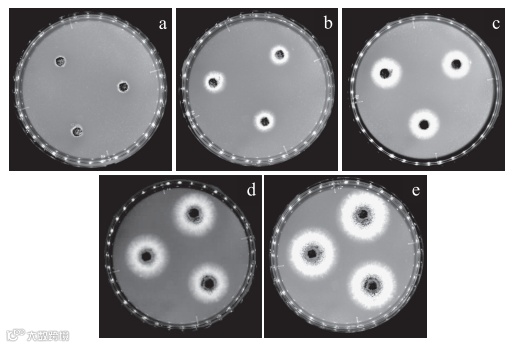

近期研究热点

利用高效液相色谱-飞行时间质谱和高效液相色谱-三重四级杆质谱检测南美白对虾的过敏原
铁观音提取物对脂多糖诱导RAW264.7细胞炎症反应的抑制作用及机制
大豆多肽营养干预对预防和治疗尾吊模拟失重大鼠肌肉萎缩的作用研究
欢迎您的来稿及阅览
《食品工业科技》官网及微信公众号免费OA阅览。
投稿网址:
http://spkj.cbpt.cnki.net/EditorB2N/quit.aspx。
联系电话:010-87244116。
QQ:郑老师1787000719。

 食品工业科技编辑部
食品工业科技编辑部

近期研究热点

利用高效液相色谱-飞行时间质谱和高效液相色谱-三重四级杆质谱检测南美白对虾的过敏原
铁观音提取物对脂多糖诱导RAW264.7细胞炎症反应的抑制作用及机制
大豆多肽营养干预对预防和治疗尾吊模拟失重大鼠肌肉萎缩的作用研究
欢迎您的来稿及阅览
《食品工业科技》官网及微信公众号免费OA阅览。
投稿网址:
http://spkj.cbpt.cnki.net/EditorB2N/quit.aspx。
联系电话:010-87244116。
QQ:郑老师1787000719。


